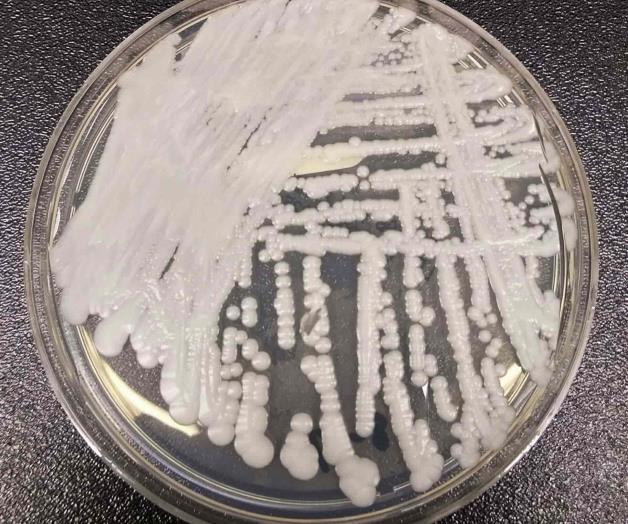
Hongos, un peligro para los enfermos

Hongos, un peligro para los enfermos
Se propaga fácilmente e infecta heridas, oídos y el torrente sanguíneo
Fotografía sin fecha proporcionada por los Centros para el Control y la Prevención de Enfermedades de Estados Unidos de una cepa de Candida auris cultivada en una placa de petri en un laboratorio de los CDC.
- NUEVA YORK, NY
Los casos de un hongo peligroso en Estados Unidos se triplicaron en solo tres años, y más de la mitad de los estados ya lo han informado, según un nuevo estudio.
La pandemia de COVID-19 probablemente impulsó parte del aumento, escribieron investigadores de los Centros para el Control y la Prevención de Enfermedades en el artículo publicado el lunes por Annals of Internal Medicine. Los trabajadores del hospital estaban tensos por los pacientes con coronavirus, y eso probablemente desvió su enfoque de desinfectar otros tipos de gérmenes, dijeron.
El hongo, Candida auris, es una forma de levadura que generalmente no es dañina para las personas sanas, pero puede ser un riesgo mortal para los frágiles pacientes de hospitales y hogares de ancianos. Se propaga fácilmente y puede infectar heridas, oídos y el torrente sanguíneo. Algunas cepas son las llamadas superbacterias que son resistentes a las tres clases de antibióticos utilizados para tratar infecciones fúngicas.
Se identificó por primera vez en Japón en 2009 y se ha visto en más y más países.
El primer caso ocurrió en 2013, pero no se informó hasta 2016. Ese año, los funcionarios de salud informaron 53 casos.
El nuevo estudio encontró que los casos continuaron disparándose, aumentando a 476 en 2019, a 756 en 2020 y luego a 1,471 en 2021. Los médicos también detectaron el hongo en la piel de miles de otros pacientes, lo que los convierte en un riesgo de transmisión a otros.
Muchos de los primeros casos en EE. UU. fueron infecciones importadas del exterior, pero ahora la mayoría de las infecciones se propagan, anotaron los autores.
